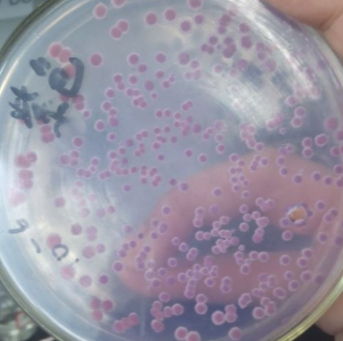
Microbacterium Testaceum

Microbacterium Testaceum 百欧博伟生物 微生物菌种
北京百欧博伟生物技术有限公司(biobw)是北京的一家专业于生物技术的研究与广泛运用及推广的高科技公司,位于北京企业林立的丰台区造甲街,生物技术推广及运用早于2011年开始,成立公司于2013年一月。本公司主要提供色谱耗材、色谱仪器、固相萃取装置、化学试剂、样品瓶、氘灯、标准品、微生物技术、菌种保藏服务以及ATCC产品代理等产品及服务。
菌种简介
平台编号:Bio-137970
规格:培养物/冻干粉
国际编号:LMG 16344
拉丁属名:Microbacterium Testaceum
用途:LMG 原装进口
注意事项:仅用于科学研究或者工业应用等非医疗目的不可用于人类或动物的临床诊断或治疗,非药用,非食用(产品信息以出库为准)
产品详情
Strain number LMG 16344
Species name Microbacterium testaceum (Komagata and Iizuka 1964) Takeuchi and Hatano 1998VP
Synonymy
Taxonomic synonyms:
- Aureobacterium testaceum
Type strain Yes
Date of entering in the collection 14/09/1995
Received as Aureobacterium testaceum
Other numbers Komagata Rp-3; Suzuki CNF 032
Other culture collection numbers CCRC 12120; IMET 10361; NCFB 2302; DSM 20166; CCUG 23849; ATCC 15829; VKM Ac-1019; CCM 2299; IFO 12675; NCIMB 11430; AJ 1466; JCM 1353; IAM 1561
Depositor Culture Collection University of Göteborg (CCUG)
Country of origin China
Biological origin paddy rice
History <- 1989, CCM <- K.Komagata (Brevibacterium testaceum)
Risk group 1
Recommended growth medium
Medium name Temperature Oxygen relationship Ingredients
Medium 1 28 °C aerobic
'Lab-Lemco' beef extract 1 g
Yeast extract 2 g
Peptone 5 g
NaCl 5 g
Agar 15 g
Distilled water 1 L
pH 7,4
Medium 185 28 °C aerobic
Pancreatic digest of casein 17 g
Papaic digest of soybean meal 3 g
Sodium chloride 5 g
Dipotassium phosphate 2,5 g
Dextrose 2,5 g
Distilled water 1 L
Warm gently until solution is complete. Sterilize by autoclaving at 121°C for 15 minutes. If needed, add 15 g agar per liter medium.
北京百欧博伟生物技术有限公司的微生物菌种查询网提供微生物菌种保藏、测序、购买等服务,是中国微生物菌种保藏中心的服务平台,并且是集微生物菌种、菌种,ATCC菌种、细胞、培养基为一体的大型微生物查询类网站,自设设备及技术的微生物菌种保藏中心!欢迎广大客户来询!